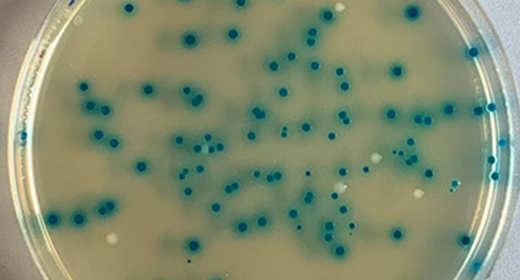
琼脂平板上的金门聚合阳性菌落

回顾NEB的最新研究
新的协议
你在进行复杂的DNA组装吗?检查我们的特色协议13-,24- 35-和52片段金门集会。

内出版
NEB的科学家利用金门组装技术,从52个DNA片段中组装出了整个噬菌体基因组。请在这里阅读预印本。

技术报告>
阅读一篇关于我们的快速HMW DNA提取流程如何用于评估Cas9靶向测序上游小鼠基因组位点的技术笔记。

白皮书
了解Primer Monitor工具如何为COVID-19诊断分析中引物/探针结合的SARS-CoV-2变异研究提供信息。

专题文章
请阅读我们在《技术网络》上的文章,了解LAMP在大流行期间的作用及其作为一种基于现场的工具的未来潜力。

新出版的
阅读我们最新一期的NEB表达,重点介绍了一个新的网络工具,一个具有7 bp识别序列的金门酶,以及令人兴奋的消息,NEB获得了认证B公司™地位。
热门话题

有特色的播客
专访Kate Creasey Krainer:促进全球农业增长
有特色的播客
专访Kate Creasey Krainer:促进全球农业增长
听听生长更多基金会(Grow More Foundation)创始人凯特·克里西·克雷纳(Kate Creasey Krainer)的看法。该基金会的使命是通过将合成生物学工具带到发展中国家,并使社区能够种植更多果实作物,帮助结束世界饥饿。

有特色的视频
COVID-19研究人员聚焦:Bijoyita Roy的采访
有特色的视频
COVID-19研究人员聚焦:Bijoyita Roy的采访
NEB高级科学家Bijoyita Roy解释了COVID-19疫苗开发的前景和时间表,重点介绍了mRNA疫苗平台以及NEB如何帮助改进mRNA疫苗的开发和生产。

有特色的网络研讨会
唾液作为SARS-CoV-2检测的样本类型
NEBinspired博客
使用大规模RNA测序来探测免疫反应,包括自身免疫性疾病和疫苗接种
贴在2021年10月13日,星期三
乔安妮·吉布森博士
研究人员正在利用一种新的批量RNA测序流程有效地探索免疫应答,该流程可以生成B或T细胞受体V(D)J和(C)区域mRNA的全长序列。这些结合了这一独特观点的发现,为以前无法回答的有关感染免疫反应和治疗干预的问题提供了线索。选择限制酶时要遵循的8个提示在体外信使核糖核酸疫苗生产
贴在2021年9月24日,星期五
作者Penny Fu Devoe, DNA克隆投资组合管理副总监&乔安妮·吉布森博士。
mRNA疫苗已经成为传统疫苗方法的替代品,因为从早期发现和开发到护理点治疗的流线型路径。在这篇文章中,阅读实用技巧,考虑当为IVT疫苗开发的关键第一步选择限制性内切酶时——将含有疫苗目标序列的质粒线性化。
病毒变异对分子检测的影响的生物信息学警报
贴在2021年8月11日,星期三
在妮可Kelesoglu
NEB生物信息学科学家Brad Langhorst博士讨论了新出现的变异对现有SARS-CoV-2分子测试的影响,这是测试失败的关键因素,他受益于使用NEB的新Primer Monitor工具,并从传染病爆发的大流行中吸取教训。












